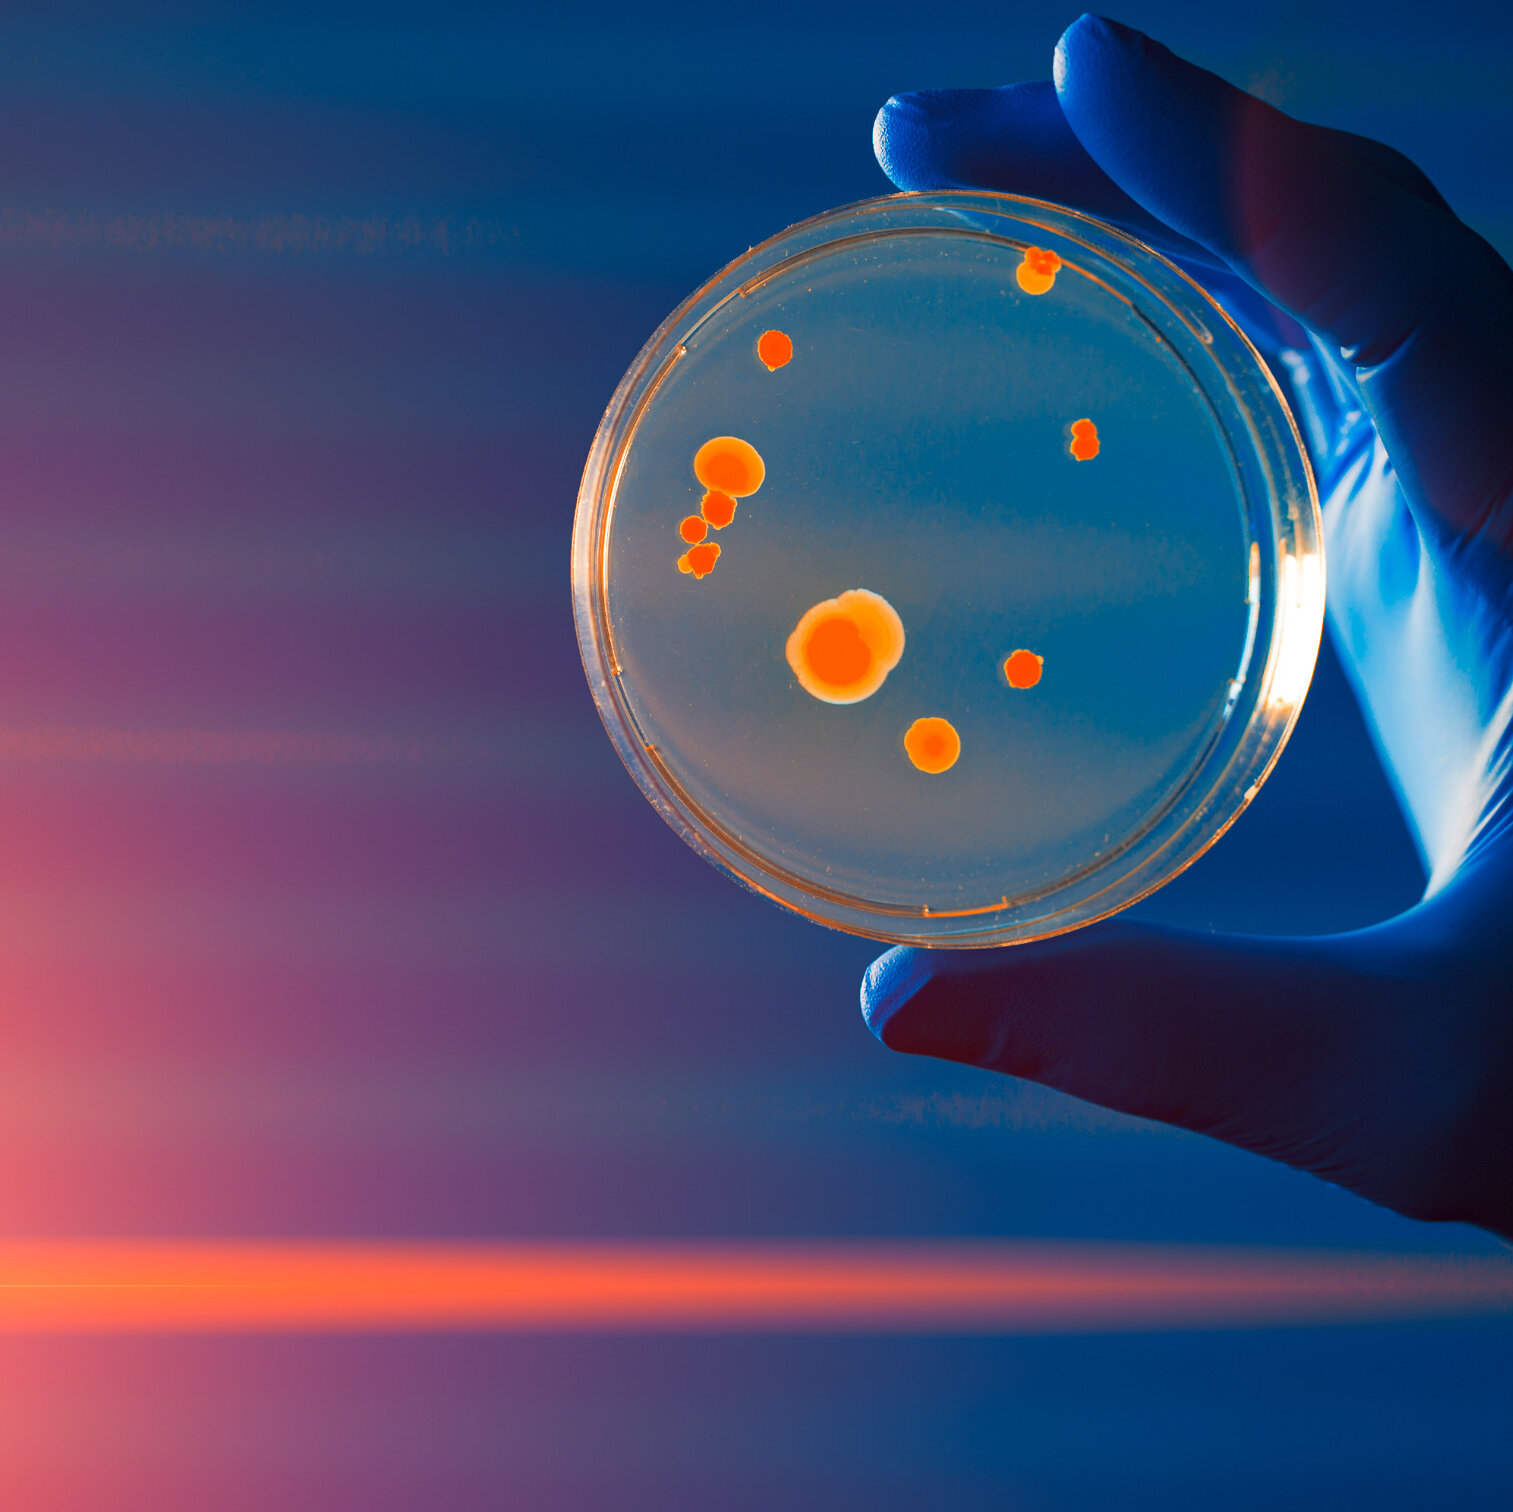

Anlagen für die pharmazeutische Industrie
Hosokawa Alpine punktet mit jahrzehntelangem Know-how in der Entwicklung von Zerkleinerungsanlagen für das sensible Umfeld der pharmazeutischen und kosmetischen Industrie. Die genaue Abstimmung der Anlagenkonfiguration mit den Prozessanforderungen sichert verlässliche und reproduzierbare Prozesse. Dies ermöglicht höchste Produktqualität – von der Entwicklung kleinster Mengen bis hin zu tonnenschweren Batchgrößen. Integrierte Containment-Lösungen sorgen für die Sicherheit des Bedienpersonals bei der Arbeit mit hochaktiven Stoffen. Zur Qualitätskontrolle stehen ausgereifte Instrumente zur Partikelanalyse zur Verfügung.